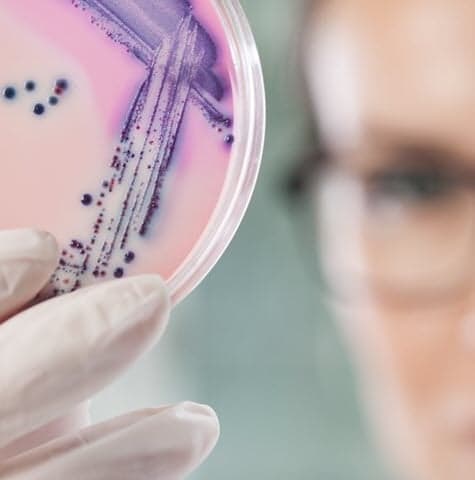
Scientist looking at microbiological sample for quality control testing

Microbiological Development and Quality Control Testing Services
Element's microbiology services provide fast, accurate, and compliant testing solutions that maintain your drug products' integrity throughout all development stages. For pharmaceutical manufacturers who demand uncompromising quality and regulatory compliance, our FDA-inspected labs and specialized CLIA-certified microbiology lab provide precise, reliable, and timely analysis from pre-clinical antimicrobial testing to commercial product release. Unlike generic laboratory services, we specialize in pharmaceutical microbiology, offering deep expertise in rapid sterility testing, USP compendial methods, and investigational compound evaluation.
What are Microbiological Development and Quality Control Testing Services at Element?
Microbiological testing ensures pharmaceutical products remain free from harmful microorganisms that could compromise product safety and efficacy. At Element, we provide comprehensive microbiology testing services that support all phases of your product and process development while maintaining product integrity. Our services help you identify and mitigate contamination risks, particularly crucial for parenteral drugs administered directly into the circulatory system.

What Can Element Offer You For Microbiological Development and Quality Control Testing Services?
Products we test
Products we test
We test a wide range of pharmaceutical products with a special focus on high-risk parenteral drugs that are administered directly into the circulatory system. Our experienced scientists work with various dosage forms including injectable and topical formulations. We also evaluate containers, closures, and filtration systems to ensure they maintain sterility throughout your product's lifecycle and prevent microbial contamination.
Key tests offered
Key tests offered
Get your products to market quickly and safely with our rapid testing solutions and comprehensive quality control capabilities designed to identify potential contamination issues before they impact your business or regulatory standing.
Rapid Sterility & Quality Control Testing:
- Sterility and rapid sterility testing - Results in as little as 24 hours for mycoplasma, 7 days for sterility testing
- Mycoplasma testing - PCR methods with 24-hour turnaround
- Microbial examination test method development and validation
- Bacterial endotoxin test method validation and testing
- Antimicrobial preservative efficacy testing
- Particulate matter testing
- Container and closure integrity testing
- Sterilization cycle development and validation
- Batch release and stability testing (both development and commercial batches)
- Filter validation bacterial retention studies
- Microbiological assays
- Special research studies
Pre-Clinical Microbiology Services (CLIA-Certified Lab):
Generate testing data for your IND submissions and investigational compound development with our CLIA-certified lab services, featuring >500,000 well-characterized isolates.
- Antibacterial/Antifungal spectrum and potency testing
- Resistance studies and kill-curve methods
- Synergy and drug interaction studies
- Methods development and quality control studies
- Bacteriophage assays and special isolate collections
Methods and solutions offered
Methods and solutions offered
Address your complex microbiology challenges with our tailored approach to method development and validation, ensuring your products meet the highest quality standards throughout their lifecycle.
Rapid Microbial Methods
We enable therapeutics and products to be delivered to patients within short shelf-life timeframes. Unlike traditional methods, our Rapid Microbial Methods provide results in as little as 24 hours. We use BacT/ALERT® 3D Dual-T, the first fully automated, growth-based, dual-temperature microbial detection system. Our comparability studies conform to USP <1223>.
At Element, we work with you to determine which method fits your needs while aligning with your shelf-life schedule.
Which labs offer this service
Which labs offer this service
Our scientists are experienced across a range of drug products and dosage forms, including parenteral and topical products. We operate under all current Good Manufacturing Practices (cGMPs), and our microbiology labs are regularly inspected by the Food and Drug Administration (FDA). Find your nearest testing location on our Locations Page.
Standards we test to and materials we test
- Current Good Manufacturing Practices (cGMPs)
- FDA regulatory requirements
- USP <61,><62>, <71>, <72>
- USP <1223> for rapid method validation
- USP <1071>
- CLIA certification standards for pre-clinical testing
Pharmaceutical Products
- Parenteral (injectable) drug products
- Topical pharmaceutical formulations
- Development and commercial batches
- Cell and gene therapies
- Antibodies and other injectables
Components and Systems
- Drug containers and closure systems
- Filters and filtration systems
- Sterilization equipment and processes
Biological Materials
- Clinical trial specimens
- Bacterial and fungal isolates
- Microbiome samples
Your Challenges, Our Solutions
Microbial Contamination Risks
Regulatory Compliance Hurdles
Need for Specialized Expertise
Complex Method Development
Why Choose Element

Compliance
Speed
Accuracy
Reliability
24hours
<10CFU
8,500+experts


Explore our global network of labs and find your nearest location
VIEW ALL LOCATIONSRelated services

Pharmaceutical Testing Services
Element leads the way in pharmaceutical testing services, delivering trusted expertise from prototype to analysis and finished product. With 150+ global pharmaceutical experts and 30+ years of experience.

Extractables and Leachables Testing Services
Element provides tailored extractables and leachables testing (E&L) studies to ensure patient safety and compliance with regulatory requirements.

Trace Metal Testing and Analysis Services
Element offers trace metal testing and impurity analysis services, addressing safety, compliance, and contamination challenges for pharmaceutical products with advanced techniques and global expertise.

Raw Materials and Excipients Testing Services
Element offers expert raw material and excipient testing services, addressing pharma industry challenges with advanced techniques to support quality, safety, and regulatory compliance throughout drug development and manufacturing.

Pharmaceutical Medical Device and Product Testing
With Element as your medical device testing partner, you’ll enjoy the benefit of a single comprehensive supplier across feasibility, R&D and prototype trials, through product development, regulatory validation and production quality control.

Material Sciences Testing
Our material testing laboratories provide a complete suite of material testing services for pharmaceutical companies.

Premier Molecular Studies and Testing Services
As a premier provider of molecular studies and testing services, Element delivers accurate and reliable results. Our CLIA-certified reference molecular lab is trusted to provide comprehensive molecular characterization of isolates.
